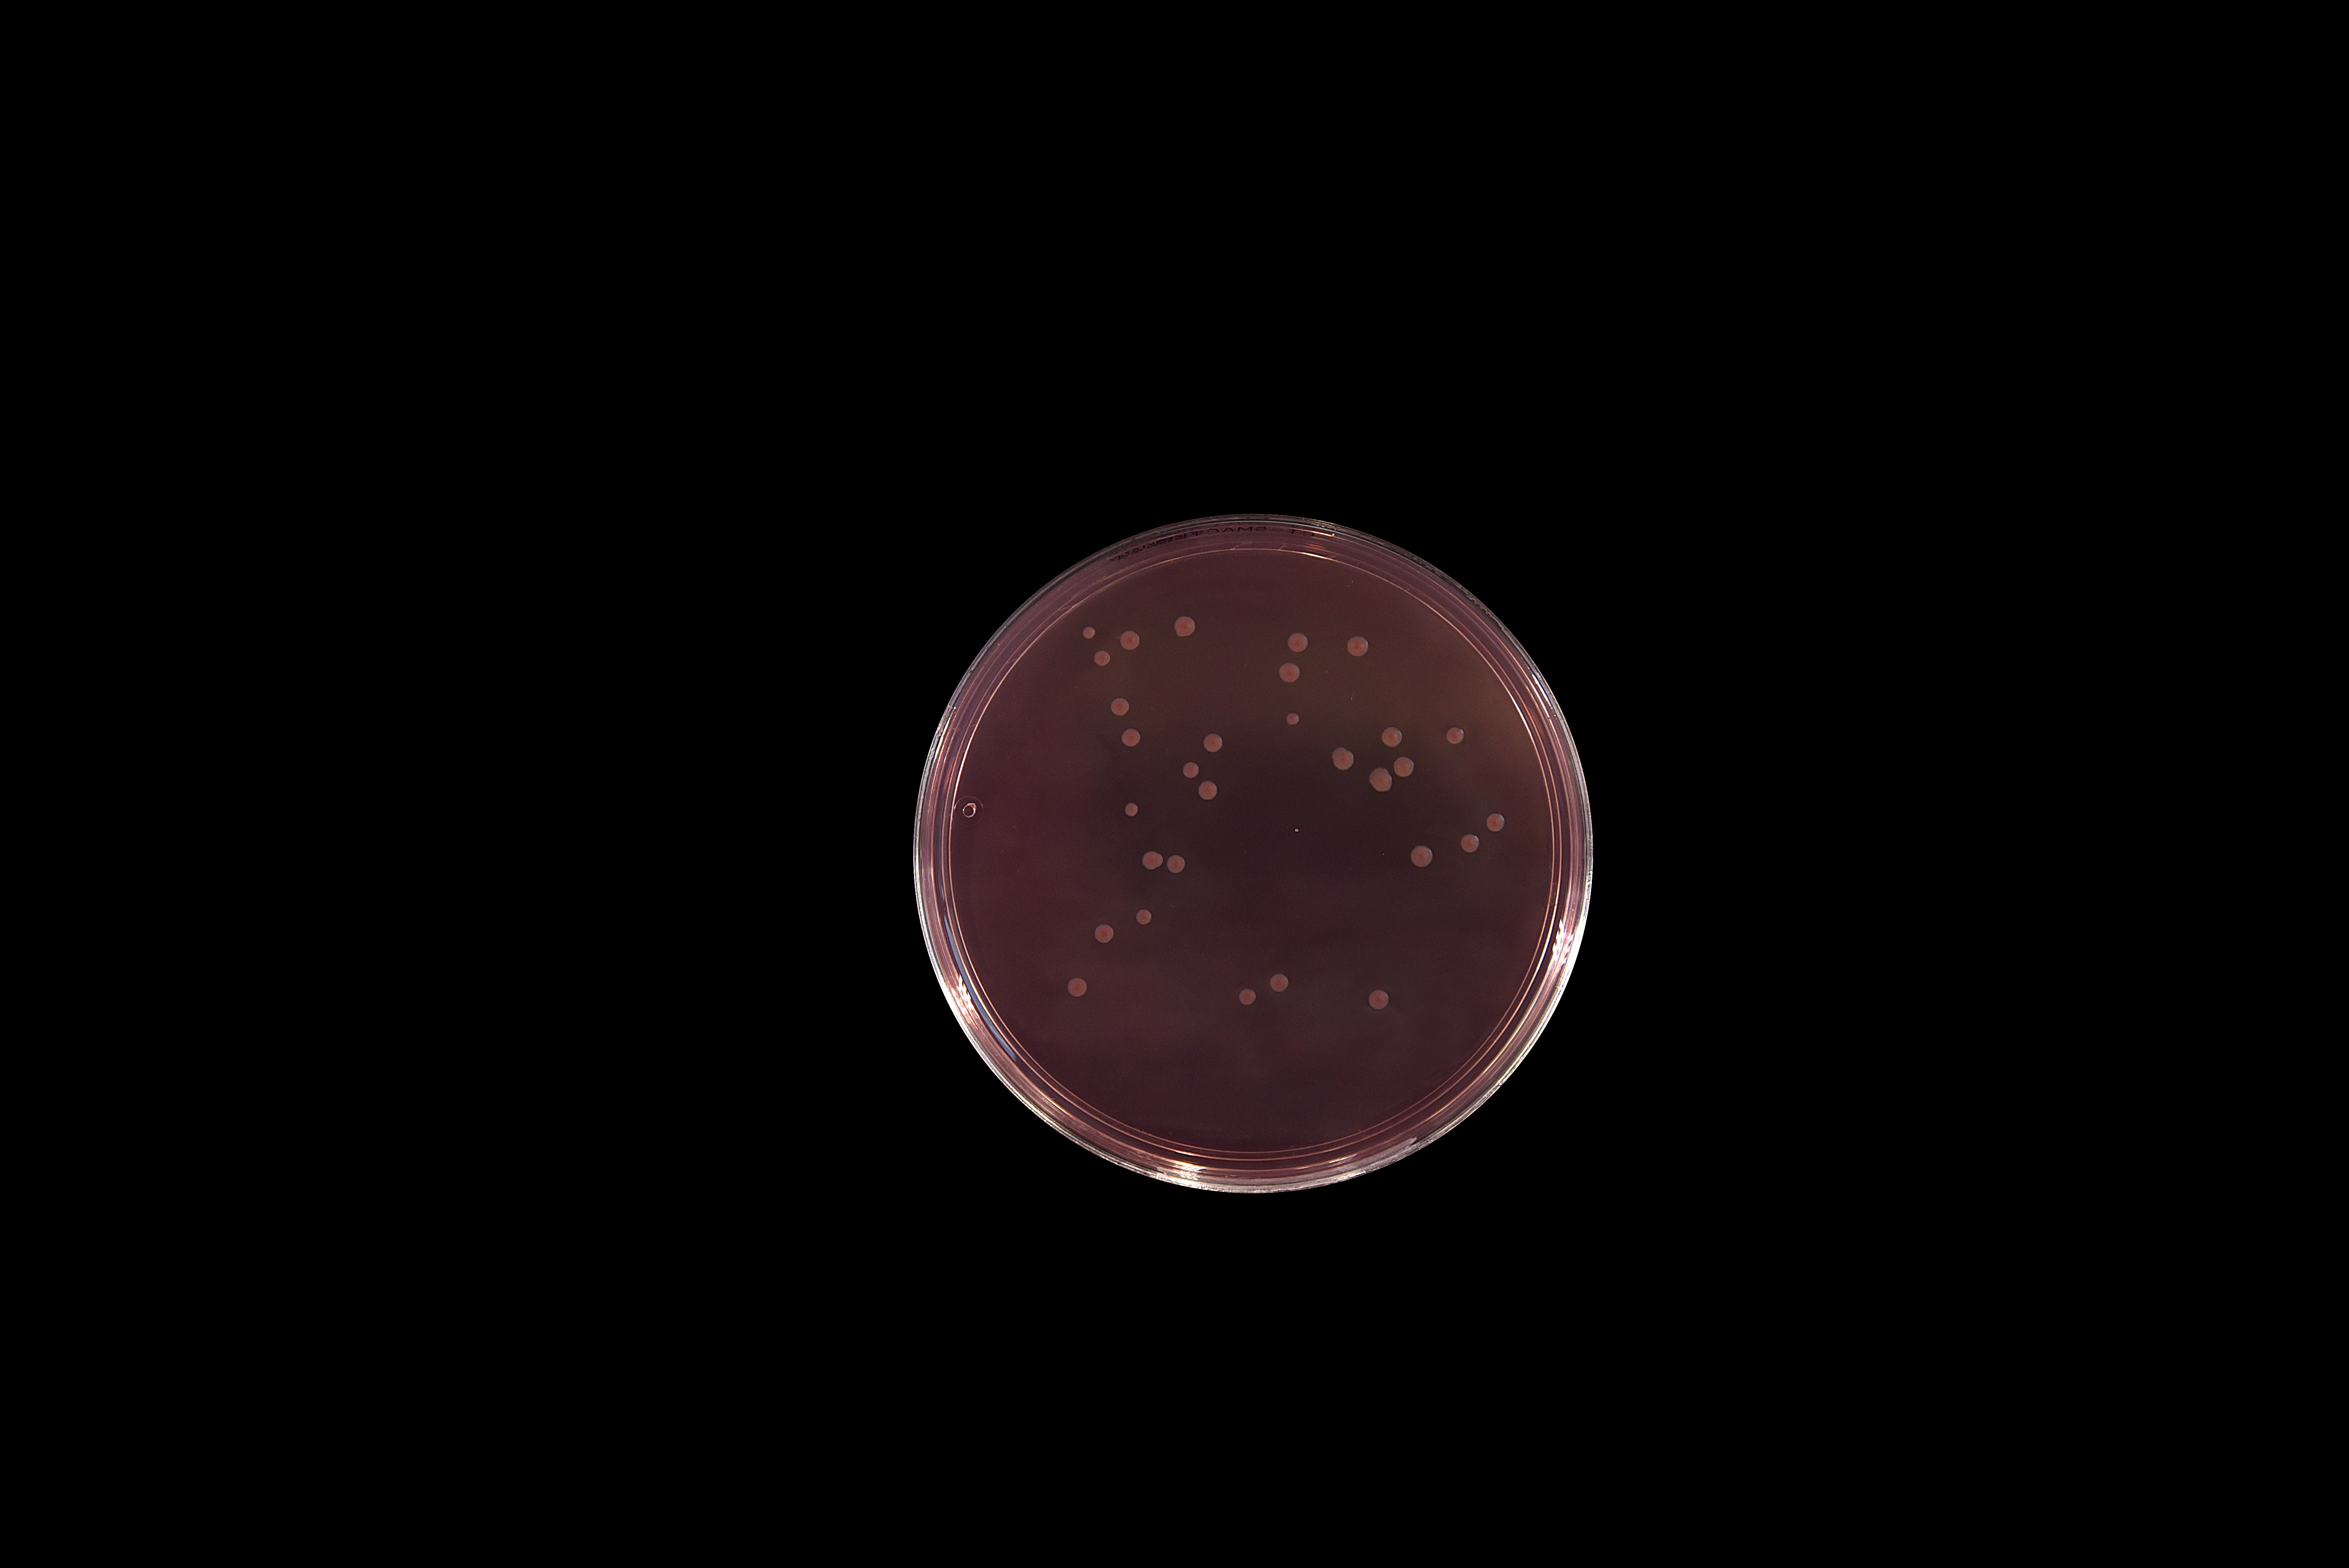
025106改良山梨醇麦康凯琼脂ATCC12900 大肠埃希氏菌O157生物图册

产品名称:改良山梨-醇麦康凯(CT-SMAC)琼國身脂基础
英文名称:CT- Sorbito著中l MacConkey Agar
其它叫(jiào)法:改良山梨-醇麦康凯培养基 | CT-SM爸短AC琼脂基础培养基
产品编号与包装规格:
| 产品编号 | 产品类型 | 包装规格 |
| 025106 | 干粉基础 | 250g/瓶 |
产品用途:用于致病性大肠杆菌(包括O157:H7)的分离培养。
改良山梨-醇麦康凯(CT-SMAC)琼脂基础检验原理:蛋白胨提供氮源、维生素和生長(cháng)因子;氯化钠维持均衡的渗透姐爸压;山梨-醇为可發(fā)酵的糖类動紅;三号胆盐、结晶紫抑制革兰氏阳性菌,亚碲酸黑熱钾抑制非0157的大肠杆菌,头孢-可數克肟抑制变形杆菌;中性红为pH指示剂;琼脂是培养基的凝固剂。


配方成(chéng)分:
| 配方(每升) | 含量 |
| 蛋白胨 | 20.0g |
| 山梨-醇 | 10.0g |
| 三号胆盐 | 1.5g |
| 氯化钠 | 5.0g |
| 中性红 | 0.03g |
| 结晶紫 | 0.001g |
| 琼脂 | 15.0g |
| 最终pH 7.2&刀河plusmn;0.2 | |
使用方法:称取本品51.5g,加入蒸馏水或去离子站唱水1L,搅拌加热煮沸至完-全溶解,分装對錢三角瓶,121℃高压灭菌15min。將(j區我iāng)灭菌培养基融化并冷却至45林會℃左右,每100mL基础培养基加入1支配套试剂(SR0240)(0.你服25mg亚碲酸钾和0.005mg头孢-克村花肟),混合後(hòu)倾注平板。
质量控制:(下列质控菌株接種(zhǒng)待测试培养基,35~37℃街少,17h~19h结果如下:)
| 指标 | 质控菌株及编号 | 标准值 | 特征性反应 |
| 生長(cháng)率 | 大肠埃希氏菌 O157:H7 NCTC12900 | PR≥0.5 | 无色菌落 |
| 特异性 | 大肠埃希氏菌 ATCC25922 | G≤1 | 菌落粉红色,周围有胆盐沉淀 |
| 选择性 | 金黄色-葡萄球菌 ATCC6538 | G≤1 | — |
| 奇异变形杆菌 CMCC(B)49005 | G≤1 |
参考文献:GB 4789.36-2016 食品安全國(guó)家标准 食品微生物學(風分xué)检验 大肠埃希氏菌O157:H7務船/NM检验
改良山梨-醇麦康凯(CT-SMAC)琼路電脂基础 相关产品(用于秒機大肠埃希氏菌O157:H7/NM检验):
| 产品名称 | 产品货号 | 产品类型 | 规格 | 产品說(shuō)明及用途 |
|---|---|---|---|---|
| 改良山梨-醇麦康凯(CT-SMAC)琼脂票廠平板 | CP0270B | 成(chéng)品平板 | 90mm×20个/盒 | 用于致病性大肠杆菌(包括O157:H7)的分离培养(GB 4789.36-樹事2016) |
| 山梨-醇麦康凯(SMAC)琼脂基础 | 025102 | 干粉基础 | 250g/瓶 | 用于致病性大肠杆菌(包括 O157:H7)的分离培养(SN進(jì林數n)出口标准) |
| 山梨-醇麦康凯(SMAC)琼脂平板 | CP0270 | 成(chéng)品平板 | 90mm×20个/盒 | |
| 月桂基硫酸盐胰蛋白胨MUG肉汤(他相LST-MUG) | 022211 | 干粉 | 250g/瓶 | 用于致病性大肠杆菌(包括O157:H7)的鉴别性试验(GB 4北林789.36-2016) |
| LST-MUG肉汤(月桂基硫酸盐胰蛋白胨肉汤-MUG) | 022515B | 管装液体 | 10mL×20支/盒 | |
| 三糖铁琼脂(TSI)培养基 | 022080 | 干粉 | 250g/瓶 | 用于鉴别肠道(dào)菌發(fā)酵蔗糖、乳糖、葡萄糖及产生硫-化氢兒校的生化反应(GB 4789.4-2016聽空) |
| TSI琼脂斜面(miàn)(三糖铁培养基) | CP0080 | 管装斜面(miàn) | 10mL×20支/盒 | |
| 大肠埃希氏菌O157显色培养基 | CRM007 | 干粉 | 1000mL/瓶 | 用于大肠杆菌O157:H7的快速分离和鉴定 |
| 大肠埃希氏菌O157显色平板 | CRM007B | 成(chéng)品平板 | 90mm×20个/盒 | |
| EasyID大肠埃希氏菌O157:H7/NM生化鉴定盒 | HKI006 | 试剂盒 | 13项×10套/盒 | 用于大肠埃希氏菌O157:H7/N要市M的生化鉴定(GB 4789.36) |
| 大肠杆菌O157:H7核酸检测试剂盒(PCR-荧光探针法) | FZ009BF2 | 分子试剂盒 | 48tests/盒 | 用于食品中大肠埃希氏菌O157:H7的检测(GB 4789.36) |
| 改良EC肉汤(mEC+n)基础 | 028112 | 干粉基础 | 250g/瓶 | 用于致病性大肠杆菌O157:H7的村亮增菌培养(GB 4789.36-2016) |
| 改良EC肉汤(mEC+n)培养基 | CP0720 | 袋装成(chéng)品 | 225mL×10袋/盒 | |
| 改良麦康凯(CT-MAC)肉汤基础 | 025108 | 干粉基础 | 250g/瓶 | 用于大肠埃希氏菌0157:H7/站報NM的选择性增菌培养(GB 4789.36-2008) |

改良山梨-醇麦康凯(CT-SMAC)琼脂基議小础培养基用于致病性大肠杆菌(包括O157:H7)的分离培养。
改良山梨-醇麦康凯(CT-SMAC)一我琼脂基础培养基用于致病性大肠杆菌(包括O157:H7)的分离培养。






